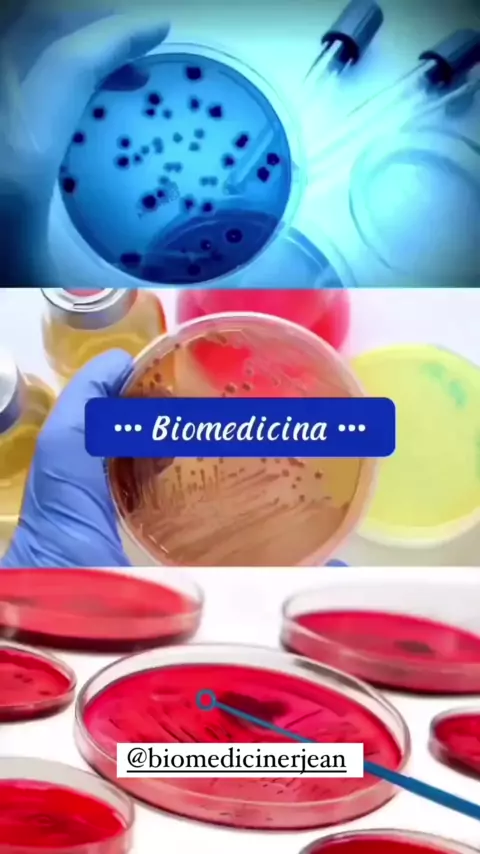

Seguir
88
2
biomedicinerjean
Um amor tão grande pela Biomedicina #biomedicina #biomed #biomediciner #biomedico
Mais
Comentar
Cancelar
Enviar

Seguir
1.3K
25
ContosPorVoz
#NarraStars Amor de mãe vai até o fim
Mais
Este conteúdo parece ter ser gerado por IA. Por favor, valide com cautela.

Seguir
4.6K
146
JOANNA.olhosdemel
Olha
Mais